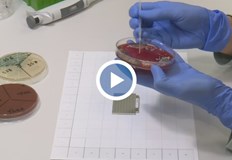
Лабораторията има готовност да бъдат назначени на работа украински специалистиРусенска медицинска

... интернет системата родителите трябва да посочат и броя на децата, въпреки че билетите за тях са с цена 0 лв., за да получат електронен билет.
Прави Безплатни - Новини
Делфинариум Варна обяви безплатен вход за деца до 12 години
...... интернет системата родителите трябва да посочат и броя на децата, въпреки че билетите за тях са с цена 0 лв., за да получат електронен билет.
Делфинариум Варна подарява безплатен билет на децата до 12 години
...... сайта, трябва да избират и броя на децата – системата ги калкулира с цена – 0 лв., но те също трябва да получат електронен билет.
Безплатни кардиологични прегледи ще се извършват в столичната Университетска многопрофилна
...... и промяна в начина на живот рискът може да бъде значително намален.През март 2025 г. в болницата беше извършена първата за тази година сърдечна трансплантация.
Непал обявява 97 върха безплатни за изкачване но прави Еверест
...... на Непал също обсъжда нов закон,който ще изисква всеки, желаещ да се изкачи на Еверест, първо да е покорил планина над 7000 м в страната.
Непал ще направи 97 от своите хималайски върхове достъпни за
...... Непал също обсъжда нов закон, който ще изисква всеки, желаещ да се изкачи на Еверест, първо да е покорил планина над 7000 м в страната.
Александровска болница в София организира безплатни изследвания за оценка на
...... човека, прави го по-слаб и неустойчив към инфекции. Традиционните методи за намаляване на теглото дават бавни резултати, което обезсърчава голям процент от хората със затлъстяване.
Добра идея се роди в София Общината ще помогне на
...... разбирайте увеличение на цените по договорите си – със заплахи, че ако не им се удовлетворят исканията, спират услугата „от понеделник“. Увеличение не се състоя.
Делфинариум Варна подарява безплатен билет на децата до 12 години
...... сайта, моля да избирате и броя на децата - системата ги калкулира с цена - 0 лв., но те също трябва да получат електронен билет.
Делфинариум Варна подарява безплатен билет на децата до 12 години
...... и да видят делфинското семейство - Доли, Йоана, Бимбо, Кимбо и Флипър. Предвидени са много игри и награди с публиката, както и богата анимационна програма.
Делфинариум Варна подарява безплатен билет на децата до 12 години
...... сайта, моля да избирате и броя на децата - системата ги калкулира с цена - 0 лв., но те също трябва да получат електронен билет.
Делфинариум Варна подарява безплатен билет на децата до 12 години
...... сайта, молим да избирате и броя на децата - системата ги калкулира с цена - 0 лв., но те също трябва да получат електронен билет.
Делфинариум Варна подарява безплатен билет на децата до 12 години
...... сайта, молим да избирате и броя на децата - системата ги калкулира с цена - 0 лв., но те също трябва да получат електронен билет.
Делфинариум Варна подарява безплатен билет на децата до 12 години
...... сайта, трябва да избирате и броя на децата - системата ги калкулира с цена - 0 лв., но те също трябва да получат електронен билет.
Търговецът на дребно Marks and Spencer от големите улици направи
...... погледнете е, че всички продукти работят по £5 всеки. Междувременно, който струва над £165, но е на цена от £42. Или можете да вземете тук.
Blizzard Entertainment обявиха че прави героите в Overwatch 2 безплатни
...... нова карта и режим. Става дума за представения по време на Blizzcon 2023 режим Clash. Заедно с него ще дойдат и две изцяло нови карти.
Делфинариум Варна организира безплатни представления за децата Ваканция с
...... танцуваме, ще играем волейбол и футбол, и ще въртим обръчи заедно с делфините. Можете да закупите своя онлайн билет тук: или на касата в деня на представлението.
Във връзка с повишената заболяемост от COVID 19 РЗИ Добрич съобщава че
...... се консултирали предварително с личния си лекар.Изследванията ще се провеждат в сградата на РЗИ-Добрич в кабинет КАБКИС от 09.00 до 11.00 часа всеки работен ден.
Делфинариум Варна организира безплатни представления за децата Ваканция с
...... волейбол и футбол, и ще въртим обръчи заедно с делфините. Можете да закупите своя онлайн билет тук: https://dolphinariumvarna.bg или на касата в деня на представлението.
Делфинариум Варна организира безплатни коледни представления за децата и на
...... тези въпроси и техните отговори, елате на 16 декември 2023 г. в „Делфинариум Варна“ и можете да спечелите някоя от специалните награди на Дядо Коледа!
Делфинариум Варна организира безплатни коледни представления за децата и на
...... тези въпроси и техните отговори, елате на 16 декември 2023 г. в „Делфинариум Варна“ и можете да спечелите някоя от специалните награди на Дядо Коледа!
Делфинариум Варна организира безплатни коледни представления за децата съобщават оттам
...... горната част на главата си, която могат да отварят и затварят, за да дишат.Колко делфина живеят в Делфинариума? Пет: Кимбо, Доли, Йоана, Бимбо и Флипър.
Делфинариум Варна организира безплатни коледни представления за децата Те ще
...... тези въпроси и техните отговори, елате на 17 декември 2023 г. в „Делфинариум Варна“ и можете да спечелите някоя от специалните награди на Дядо Коледа!
Хроничните белодробни заболявания бележат внушителния 163 ръст за последните 30
...... се реимбурсира от НЗОК, като домашната кислородотерапия и неинвазивната вентилация остават за сметка на болните, които в повечето случаи няма как да си ги позволят.
TD Хроничните белодробни заболявания бележат внушителния 163 ръст за последните 30
...... се реимбурсира от НЗОК, като домашната кислородотерапия и неинвазивната вентилация остават за сметка на болните, които в повечето случаи няма как да си ги позволят.
Хроничните белодробни заболявания бележат внушителния 163 ръст за последните 30
...... се реимбурсира от НЗОК, като домашната кислородотерапия и неинвазивната вентилация остават за сметка на болните, които в повечето случаи няма как да си ги позволят.
Хроничните белодробни заболявания бележат внушителния 163 ръст за последните 30
...... се реимбурсира от НЗОК, като домашната кислородотерапия и неинвазивната вентилация остават за сметка на болните, които в повечето случаи няма как да си ги позволят.
Младите хора във Франция ще имат безплатен достъп до презервативи
...... включват безплатна спешна контрацепция за всички жени в аптеките и безплатни прегледи за ППИ без рецепта, с изключение на ХИВ, за тези под 26 години.
Куриерската платформа Glovo обяви началото на социална програма насочена към
...... края на годината се очаква да обхване над 22 000 куриери. До края на 2023 г. Glovo планира да въведе програмата на всички свои пазари.
Мобилен екип на РЗИ Ямбол ще извършва тестове и
...... кметовете на петте общини в област Ямбол. Желаещите имунизация може да се обръщат към кметовете на населените места или директно в РЗИ-Ямбол на телефон 046-663170.
Добра новина за ползвателите на обществения транспорт в Испания
...... пътуваниятаа. Ходът, който се подкрепя от германското правителство, има за цел да примами местните обратно към железопътния транспорт, но е отворен и за международни посетители.
Лаборатория в Русе ще прави при необходимост безплатни изследвания на
...... на дарителската кампания на БЧК за Украйна.Посетете КИС 13 на https://kiss13.net и във Facebook: https://facebook.com/kiss13tv/ Виж още новини от Русе, Разград и Търговище на https://kiss13.net/
Лабораторията има готовност да бъдат назначени на работа украински специалистиРусенска медицинска
...... на работа украински специалисти, предаде .Лабораторията разполага и с един от двата най-модерни за страната апарати за микробиологични анализи, който прави прецизни изследвания за броени минути.
Русенска медицинска лаборатория предлага безплатни изследвания за бежанци от Украйна
...... и с един от двата най-модерни за страната апарати за микробиологични анализи, който прави прецизни изследвания за броени минути.Повече разберете във видеото. Репортер: Роман Сушков
Повикванията няма да бъдат таксувани независимо дали са към мобилни
...... така и във фиксираната. Повикванията няма да бъдат таксувани независимо дали са към мобилни или стационарни номера в Украйна от днес до 10-ти март
В знак на солидарност с украинския народ и като израз
...... мрежа, така и във фиксираната. Повикванията няма да бъдат таксувани независимо дали са към мобилни или стационарни номера в Украйна от днес до 10-ти март.
Взнак на солидарност с украинския народ и като израз на
...... мобилната си мрежа, така и във фиксираната.Повикванията няма да бъдат таксувани независимо дали са към мобилни или стационарни номера в Украйна от днес до 10 март.
Д р Явор Малинов ще извършва безплатни консултации по репродуктивно здраве
...... напълно безплатни и ще започнат от 10 часа. Желаещите да се прегледат могат да запишат своя час, като позвънят на следния телефон: 088 888 2951.
Черногорското здравно министерство съобщи днес че 13 май Институтът за
...... час и се удължава с един час времето за жива музика в откритите градини на заведенията, която сега е разрешена от 19 до 22 часа.
На всички пристигащи пътници на международното летище в Абу Даби
...... Ако човекът остане в Абу Даби в продължение на четири дни или повече, той трябва да направи друг PCR тест на четвъртия и осмия ден.
1054 1097 1077 1077 1076 1085 1072 1083 1072 1073 1086 1088 1072 1090 1086 1088 1080 1103 1074 1056 1091 1089 1077 1074 1077 1095 1077 1087 1088 1072 1074 1080 1073 1077 1079 1087 1083 1072 1090 1085 1080 PCR 1090 1077 1089 1090 1086 1074 1077
...... остават затворени до Нова година Проф.Кантарджиев: Ваксината трябва да е брилянтна, за да я разреши ЕК Повече за Коронавирус най-ново: лесни стъпки: просто ръководство: eпидемия:
отландия стана първата държава в света която направи продуктите за
...... област, която законопроектът има за цел да разгледа: Изследователите установяват, че близо половината от анкетираните момичета са пропуснали училище по време на периода на менструация.
Шотландия се превърна в първата държава в света която направи
...... казват, че това е проблем за младите момичета. Установено е, че 71% от 14-21 годишните се чувстват неудобно да купуват продукти за менструалния си цикъл.
Рори този кратък псевдоним започна да се появява все
...... и приемане на достатъчно вода, защото когато човек захранва тялото си качествено, става по-жизнен и щастлив! В комбинация с редовните тренировки – всичко се подрежда!
Унгария ще направи държавни шест от най големите частни клиники за
...... всяко време на дежурния редактор!За реклама виж - https://petel.bg/advertising-rates.html-->-->-->-->рекламаКоментариКоментирай чрез FacebookЗа да пишете коментари, моля регистрирайте се за секунди ТУКНапиши коментарИме:Коментар:Последни новинирекламаФорумФорум--> -->рекламареклама За Петел|Рекламни тарифи|
Мобилен камбинет ще извършва безплатни и анонимни изследвания за ХИВ
...... университет ще се проведат информационни кампании с предоставяне на възможност за безплатно и анонимно изследване за ХИВ и хепатит С в мобилен медицински кабинет. /moreto.net
Жители на 120 населени места в България ще имат възможност
...... все по-млади пациенти да се оплакват от хипертония. Това е и причината екипите на „Агрион“ да насочат усилията си към изследване именно на тези болести.
1055 1072 1088 1090 1080 1103 1090 1072 1044 1072 1081 1041 1098 1083 1075 1072 1088 1080 1103 1087 1088 1086 1074 1077 1076 1077 1087 1098 1088 1074 1080 1090 1077 1086 1085 1083 1072 1081 1085 1074 1098 1090 1088 1077 1096 1085 1080 1080 1079 1073 1086 1088 1080 1079 1072 1076 1072
...... със сигурност в предстоящите евроизбори българските избиратели ще могат да гласуват и за кандидат, привърженик на легализирането на еднополовите бракове и у нас.
Ако по някаква причина сте си закупили Battlefield 1 но
...... на следващата игра от поредицата, което беше забавено. Както вероятно знаете, излизането на Battlefield V беше преместено от октомври за ноември, и по-точно за 20.11.
Жителите на 157 населени места в България ще получат безплатни
...... самолечение, което може да се окаже фатално. За това медицинските екипи ще дават и конкретни препоръки на всички, които се подложат на изследвания.
.jpg?17:37:22)


.jpg?15:30:42)